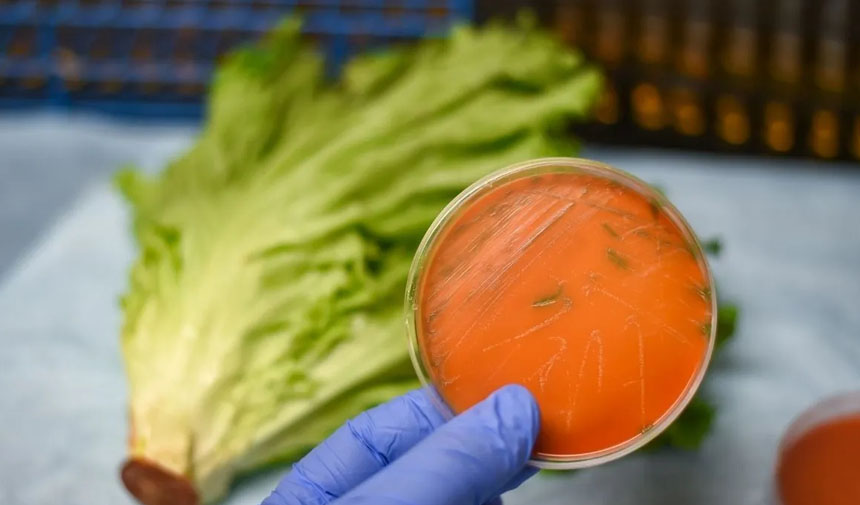

12 ÇEŞİT ÜRÜN GERİ ÇAĞRILDI
Albertsons’un hazır yemek ve şarküteri ürünlerinde listeria monocytogenes bakterisi tespit edilmesinin ardından 12 çeşit ürünü geri çağrıldı.
ŞİRKET MÜŞTERİLERİNE BİR DUYURU YAYIMLADI
Amerika Birleşik Devletleri (ABD) Tarım Bakanlığı Gıda Güvenliği ve Denetim Servisi rutin testlerinde hazır tavuk ürününde kontaminasyon tespit etmesinin ardından şirket müşterilerine bir duyuru yayımladı.
ŞİRKET HANGİ ÜRÜNLERİN SATIŞINI YAPIYOR?
Fırın, süt ürünleri, şarküteri, dondurulmuş gıdalar, genel market, et, eczane, ürün, deniz ürünleri, atıştırmalıklar, içki gibi ürünlerinin satışını yapan Albertsons, ürünlerini kullananların listeria monocytogenes bulaşma riski olduğunu duyurdu.
RUTİN TESTLERİNDE BAKTERİ TESPİT EDİLDİ
Geri çağırma, ABD Tarım Bakanlığı Gıda Güvenliği ve Denetim Servisi’nin (FSIS) rutin testlerinde Oklahoma’daki BrucePac’in hazır tavuk ürününde kontaminasyon tespit etmesinin ardından Fresh Creative Foods’un harekete geçmesiyle başlatıldı. Geri çağrılan ürünler Kaliforniya, Teksas, Illinois ve Washington dahil olmak üzere birçok eyalette Albertsons, Safeway, Jewel-Osco ve Vons mağazalarında satıldı.
ŞİRKETTEN TIBBİ YARDIM UYARISI
Şirket, risk altındaki kişilerin kontamine gıda tüketiminden sonra grip benzeri semptomlar yaşamaları durumunda tıbbi yardım almalarını önerdi.
BAZI GRUPLARDA CİDDİ ENFEKSİYONLARA NEDEN OLABİLİYOR
Listeria monocytogenes sıklıkla toprak ve suda bulunuyor. Listeria, yaşlılar, küçük çocuklar ve hamileler gibi hassas gruplarda ciddi enfeksiyonlara neden olabiliyor. Ateş, mide bulantısı ve şiddetli vakalarda düşük gibi semptomlara yol açıyor.